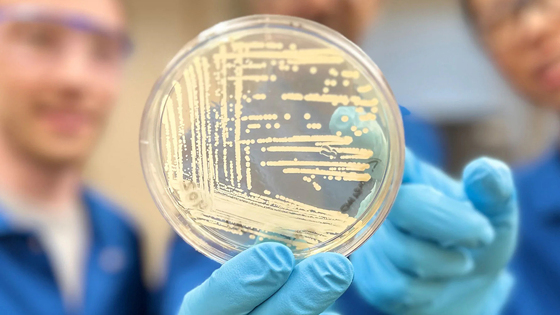

Разработано средство-«бульдог», которое уничтожает даже устойчивые к антибиотикам бактерии
Новая синтетическая молекула крезомицин, судя по испытаниям, убивает устойчивые к лекарствам штаммы бактерий, которые ежегодно уносят более миллиона жизней. Оно оказалось более успешно, чем существующие антибиотики, из-за особого способа воздействия на микроорганизмы. Об открытии сообщает Гарвардский университет (США).
Разработчики отталкивались от химической структуры линкозамидов – широко распространенного класса антибиотиков. В него входит и часто назначаемый сейчас клиндамицин, который, как и многие современные препараты, является модифицированным природным веществом.
Особенность нового соединения, полученного гарвардскими учеными, в том, что вещество полностью создано искусственно – и за счет этого удалось изначально заложить в него нужные свойства.
Новая молекула, судя по проведенным тестам, может лучше связываться с рибосомами – это части клеток бактерий, которые контролируют синтез белка. По большому счету, именно нарушение функции рибосом является механизмом действия антибиотиков. Однако, у некоторых бактерий развились защитные механизмы от существующих сейчас лекарств.
Отличие воздействия крезомицина в том, что он изначально нацелен на то, чтобы «вцепиться» в рибосому. А особая форма молекулы обеспечивает более крепкое соединение с рибосомами – и ферменты, выделяемые бактериями для защиты, не могут разорвать эту связь.
«Хотя мы еще не знаем, являются ли крезомицин и подобные ему препараты безопасными и эффективными для людей, наши результаты показывают значительно более высокую, по сравнению с клинически одобренными антибиотиками, ингибирующую активность (подавляющую химические реакции – прим. Ред.) против длинного списка патогенных бактериальных штаммов, которые убивают более миллиона человек каждый год», — говорит профессор химии и химической биологии Эндрю Майерс.
По расчетам ученых, такой препарат поможет бороться со многими супербактериями и штаммами болезнетворных микроорганизмов, устойчивыми к уже имеющимся натуральным или полусинтетическим веществам. В их числе золотистый стафилококк и синегнойная палочка. Это важно, так как число резистентных к антибиотикам бактерий растет, и без лекарства против них могут стать невозможными проведение операций, лечение рака, трансплантация органов и другие медицинские манипуляции.
При этом в разработке у команд Майерса находятся еще несколько перспективных соединений, которые могут оказаться эффективными против супербактерий. Ученые ищут их с помощью авторской методики: они синтезируют не всю молекулу разрабатываемого препарата сразу, а отдельные составляющие. А затем, как конструктор Lego, собирают из них множество вариантов молекулы, свойствах которых могут отрегулировать заранее. Это позволяет тестировать сразу большое число потенциально эффективных веществ.